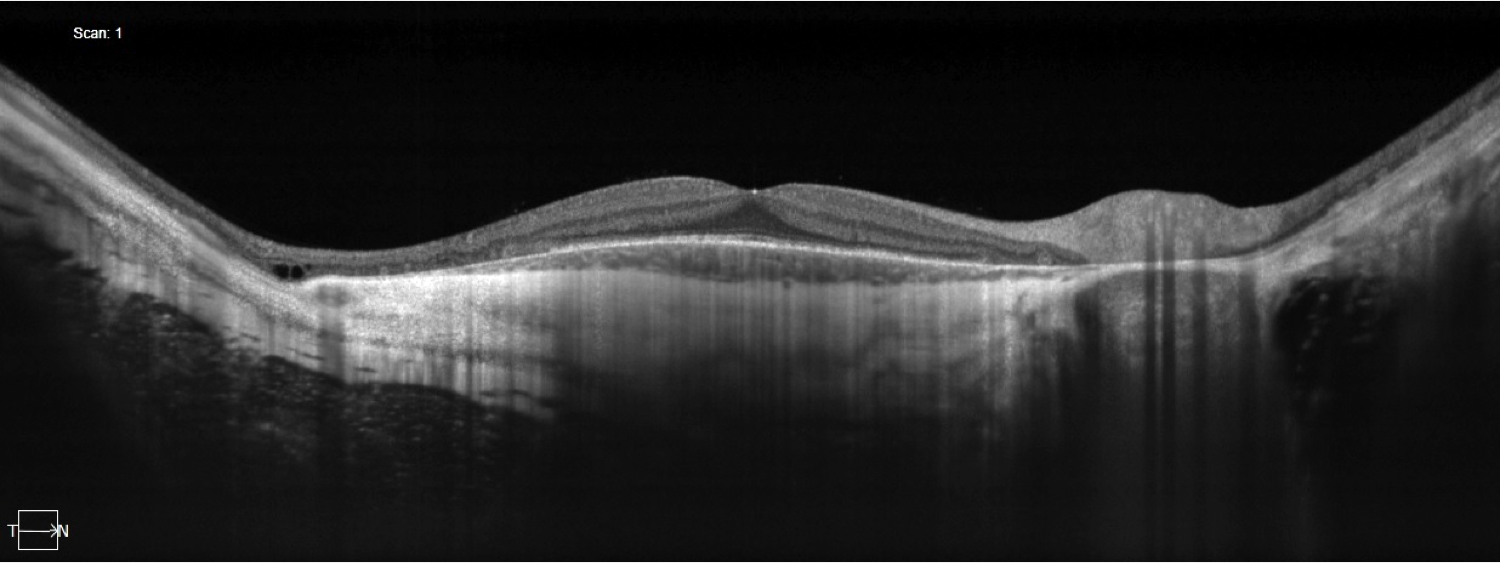

Big 14 Self-Assessment
Case 1
Case 1 is a 19 year old man with 20/20 acuity. He first came to medical attention at age 9 when nummular patches of choroidal atrophy were detected in the periphery of his fundus. His mother and maternal grandmother have completely normal vision but both of them have an unusual “mudspattered” appearance to their retinas.